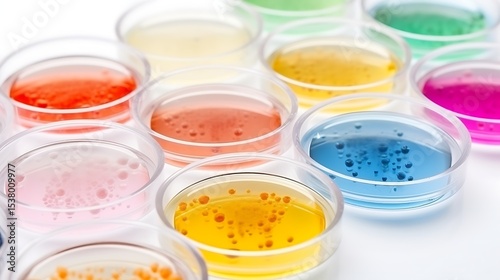

Download sample
File Details
Published: 2025-06-17 08:34:10.756767 Category: Hobbies and Leisure Type: Photo Model release: NoShare
Colorful petri dishes arranged in a row with visible microbial growth, solid off-white background.
Contributor: Perfect Art
ID : 1538009977
